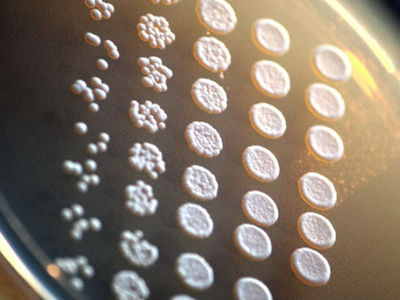

-Метки
-Новости
СМИ: Россия передала Евросоюзу свой "черный список" - (0)
Уэбб и Фигередо лишены постов вице-президентов ФИФА - (0)
Сильное землетрясение произошло в океане к югу от Токио. Угрозы цунами нет - (0)
Украинские хирурги прооперировали задержанных Александрова и Ерофеева - (0)
Глава УЕФА Платини возглавил оргкомитет чемпионата мира-2018 - (0)
-Видео

- Невеста сказала НЕТ в ЗАГСе!
- Смотрели: 170 (4)

- Тебе грустно и одиноко? Звони!
- Смотрели: 7 (2)

- ТАК МОГУТ ТОЛЬКО РУССКИЕ!!! Смотрите до
- Смотрели: 29 (1)

- Симпотичная девушка и красный чемодан
- Смотрели: 61 (2)
-Поиск по дневнику
-Статистика
Улюкаев рассказал о сингапурских рецептах |
 После визита министра экономического развития Алексея Улюкаева в Брюссель на российско-европейско-украинские переговоры в некоторых газетах появилась информация, что Россия уже не настаивает на отсрочке вступления в действие украинско-европейского Соглашения об ассоциации, которое, как известно, еще как меняет режим российско-украинской торговли. Возникает вопрос: а что же тогда столько копий было сломлено, особенно в зиму 2013-2024 годов?
После визита министра экономического развития Алексея Улюкаева в Брюссель на российско-европейско-украинские переговоры в некоторых газетах появилась информация, что Россия уже не настаивает на отсрочке вступления в действие украинско-европейского Соглашения об ассоциации, которое, как известно, еще как меняет режим российско-украинской торговли. Возникает вопрос: а что же тогда столько копий было сломлено, особенно в зиму 2013-2024 годов?
|
Метки: правительство технологии совещание экономика Мединский министры украинцы политика россияне Украина Улюкаев семинар новости санкции Google рассказал |
Три напряженных года: Медведев рассказал, как правительство движется к намеченной цели |
 Члены правительства РФ во главе с премьер-министром Дмитрием Медведевым обсудили в неформальной обстановке итоги своей работы за три года, текущее экономическое положение, планы на будущее, а также ситуацию на Украине. О подробностях встречи Дмитрий Медведев рассказал в интервью "Вестям в субботу".
Члены правительства РФ во главе с премьер-министром Дмитрием Медведевым обсудили в неформальной обстановке итоги своей работы за три года, текущее экономическое положение, планы на будущее, а также ситуацию на Украине. О подробностях встречи Дмитрий Медведев рассказал в интервью "Вестям в субботу".
|
|
Молодые интеллектуалы России представили в Томске новые инновационные разработки |
 Томск на этой неделе стал центром притяжения интеллектуальной молодёжи со всей страны.
Томск на этой неделе стал центром притяжения интеллектуальной молодёжи со всей страны.
|
Метки: импортозамещение разработка инновации политика молодежь новости ЮНОВУС россия форум томск Вести 150 Молодые интеллектуалы |
Понравилось: 1 пользователю
В Севастополе открылся кинофорум "Золотой Витязь" |
 Кинофорум "Золотой Витязь" открылся в Севастополе. Среди гостей фестиваля — звезды российского кино, театра и музыки, делегаты из зарубежья. Местные жители устроили им тёплый приём во время церемонии открытия, а проход по красной ковровой дорожке сопровождался игрой флотского оркестра, передает телеканал "Россия 24".
Кинофорум "Золотой Витязь" открылся в Севастополе. Среди гостей фестиваля — звезды российского кино, театра и музыки, делегаты из зарубежья. Местные жители устроили им тёплый приём во время церемонии открытия, а проход по красной ковровой дорожке сопровождался игрой флотского оркестра, передает телеканал "Россия 24".
|
Метки: севастополь фестиваль кустурица кинофорум политика россияне новости николай конкурс бурляев Россия фильм Вести кино Севастополе |
Понравилось: 1 пользователю
Михайловский чернозем воруют и продают за миллионы |
 Расхитители рязанского чернозема могут получить удар, которого, кажется, уже и не ждут. Если Госдума одобрит инициативу, то у них будут отнимать спецтехнику. Долгое время воры остаются фактически безнаказанными, хотя имена причастных к вывозу плодородного слоя почвы хорошо известны. За годы, что с ними идет борьба, они успели обогатиться: рязанский чернозем — золото агропромышленности.
Расхитители рязанского чернозема могут получить удар, которого, кажется, уже и не ждут. Если Госдума одобрит инициативу, то у них будут отнимать спецтехнику. Долгое время воры остаются фактически безнаказанными, хотя имена причастных к вывозу плодородного слоя почвы хорошо известны. За годы, что с ними идет борьба, они успели обогатиться: рязанский чернозем — золото агропромышленности.
|
|
Ирландия проведет референдум о равноправии традиционных и однополых браков |
 Плебисцит о равноправии традиционных и однополых браков планируют провести в Ирландии. Он может стать переломным событием в истории католической страны, поскольку по итогам голосования права гомосексуальных пар могут быть закреплены в Конституции.
Плебисцит о равноправии традиционных и однополых браков планируют провести в Ирландии. Он может стать переломным событием в истории католической страны, поскольку по итогам голосования права гомосексуальных пар могут быть закреплены в Конституции.
|
|
Понравилось: 1 пользователю
Незаконная добыча полезных ископаемых разрушает плодородные почвы Дона |
 Незаконная добыча полезных ископаемых разрушает плодородные почвы Дона. Только за последний год в Ростовской области выявлено около двухсот случаев незаконного недропользования. Фирмы, не имеющие лицензии, наносят непоправимый вред плодородию почвы. В результате таких раскопок рекультивация земли обходится муниципальным властям в круглую сумму. Об этом в Каменском районе говорили представители регионального правительства.[more]
Незаконная добыча полезных ископаемых разрушает плодородные почвы Дона. Только за последний год в Ростовской области выявлено около двухсот случаев незаконного недропользования. Фирмы, не имеющие лицензии, наносят непоправимый вред плодородию почвы. В результате таких раскопок рекультивация земли обходится муниципальным властям в круглую сумму. Об этом в Каменском районе говорили представители регионального правительства.[more]
Вгрызаясь огромным ковшом в дроблёную скальную породу, экскаватор отгружает очередные центнеры одного из главных полезных ископаемых Ростовской области. Именно на этом камне стоят десятки гидро- и атомных электростанций по всей стране, им выстлано русло Волгодонского канала, он — в основе сотен километров железнодорожных и автомобильных магистралей. У Репнянского карьероуправления, более 60 лет ведущего добычу на этом месторождении, хорошие времена. Строительный бум. Отгружали продукцию на олимпийские объекты, теперь готовятся поставлять материал для строительства крымского моста через Керченский пролив.
"Ежесменно можем добывать до 4 тысяч тонн. Производим камень и щебень различных фракций. По желанию заказчика можем регулировать и фракцию щебня, и фракцию камня, и камень негабарит, который применяется на гидросооружениях", — пояснил генеральный директор ЗАО "Репнянское карьероуправление" Владимир Коновалов.
Это предприятие — положительный пример, один из немногих в области. По количеству нарушений добыча полезных ископаемых — одна из самых проблемных отраслей. Поэтому на Дону создали специальный координационный совет и межведомственную комиссию. "Они платят налоги, у них почти 300 человек работает, за аренду земли платят. Всё как положено. А вот рядом находится ряд мест, где в чёрную добывают эту пластушку, которая спросом очень пользуется, другие виды камня. Они не платят налоги, у них работают люди за незаконную зарплату, незаконно используют землю. И самое главное, посмотрите, что там остаётся", — говорит заместитель губернатора Ростовской области Вячеслав Василенко.
Предприятия, дорожащие своей лицензией, обязательно рекультивируют отработанные карьеры. А так называемые чёрные копатели оставляют после себя практически лунный пейзаж. На заседании комиссии организуют видеосвязь с районами, где выявлено больше других нарушений законодательства о недропользовании — Красносулинский, Каменский, Белокалитвинский. Призывают к ответу глав территорий и требуют усилить взаимодействие надзорных органов и власти.
Ситуация требует срочного и жёсткого вмешательства. Это подтверждают цифры статистики. Только за последний год выявлено около двухсот случаев незаконного недропользования. Причём в половине из них самовольная добыча полезных ископаемых проводилась на землях сельхозназначения. Плодородного слоя почвы лишилось около полутора сотен гектаров.
Какое ваше мнение об этом?
А также - смотрите:
|
|
Актер Килин, обвиняемый в убийстве и изнасиловании, поменял свои показания |
 Актер сериала "Реальные пацаны" Александр Килин, обвиняемый в изнасиловании и убийстве 19-летней девушки, отрицает свою вину. Об этом ТАСС сообщил сотрудник пресс-службы Пермского краевого суда Илья Ванцовский по итогам предварительного слушания.
Актер сериала "Реальные пацаны" Александр Килин, обвиняемый в изнасиловании и убийстве 19-летней девушки, отрицает свою вину. Об этом ТАСС сообщил сотрудник пресс-службы Пермского краевого суда Илья Ванцовский по итогам предварительного слушания.
|
|
Во всех школах Забайкалья прошел последний звонок |
 Последний звонок 22 мая прошел во всех школах Забайкальского края. В этом году он прозвучал для шести тысяч выпускников. В читинскую школу № 30 ребят лично пришли поздравить первые лица края.
Последний звонок 22 мая прошел во всех школах Забайкальского края. В этом году он прозвучал для шести тысяч выпускников. В читинскую школу № 30 ребят лично пришли поздравить первые лица края.
|
|
Классный мультик "Большой кролик Бак" |
|
Метки: мультик мульт кролик большой кролик кролик бак мультики видео классный мульт мультфильм мультфильмы мульты животные приколы |
Дрожжи с человеческими генами живут даже лучше, чем без них |
Новое исследование наглядно демонстрирует, что столь разные организмы, как дрожжи и люди, имеют сильную генетическую связь. В рамках своего эксперимента специалисты по синтетической биологии внедрили в геном дрожжей 414 человеческих генов по одному и обнаружили, что гены Homo sapiens помогают грибам выжить.
Новое исследование наглядно демонстрирует, что столь разные организмы, как дрожжи и люди, имеют сильную генетическую связь. В рамках своего эксперимента специалисты по синтетической биологии внедрили в геном дрожжей 414 человеческих генов по одному и обнаружили, что гены Homo sapiens помогают грибам выжить.
|
|
Песков: Путин остается некомфортным лидером для Запада |
 Кремль удивлен скоординированностью поступающих из американских и британских СМИ запросов о президенте РФ Владимире Путине и его приближенных, несмотря на попытки Москвы наладить диалог с западными странами. Об этом пресс-секретарь главы государства Дмитрий Песков заявил журналистам, комментируя два таких запроса, поступивших в пресс-службу.
Кремль удивлен скоординированностью поступающих из американских и британских СМИ запросов о президенте РФ Владимире Путине и его приближенных, несмотря на попытки Москвы наладить диалог с западными странами. Об этом пресс-секретарь главы государства Дмитрий Песков заявил журналистам, комментируя два таких запроса, поступивших в пресс-службу.
|
Метки: пресс-секретарь президент политика владимир запросы новости санкции дмитрий россия Песков европа Путин запад Вести ТАСС |
Ополченцы нашли тела трех украинских военных в аэропорту Донецка |
 На территории Донецкого аэропорта нашли тела трех украинских военных во время исследования останков временных захоронений. Об этом сообщила член Комиссии по делам военнопленных провозглашенной Донецкой народной республики Лилия Родионова.
На территории Донецкого аэропорта нашли тела трех украинских военных во время исследования останков временных захоронений. Об этом сообщила член Комиссии по делам военнопленных провозглашенной Донецкой народной республики Лилия Родионова.
|
Метки: захоронения политика украинцы конфликт передача обстрелы аэропорт Украина красный новости обстрел военных басурин донецк эдуард Ополченцы нашли |
Яценюк: не надо бояться Россию. Это она должна нас бояться |
 Украинские политики продолжают радовать нас своими заявлениями, направленными в адрес западного сообщества. Не успели представители НАТО откреститься от предложения главы СНБО Украины Турчинова разместить на территории страны американские ПРО, как вслед за ним премьер Арсений Яценюк решил ободрить лидеров Евросоюза призывом к расширению без оглядки на Москву.[more]
Украинские политики продолжают радовать нас своими заявлениями, направленными в адрес западного сообщества. Не успели представители НАТО откреститься от предложения главы СНБО Украины Турчинова разместить на территории страны американские ПРО, как вслед за ним премьер Арсений Яценюк решил ободрить лидеров Евросоюза призывом к расширению без оглядки на Москву.[more]
"Действуйте смело и мудро. Не бойтесь России. Это Россия должна бояться вас, каждого из нас", — заявил он в интервью газете Financial Times в преддверии проходящего сейчас в Риге саммита "Восточного партнерства".
"Пусть вас не пугает глобальное расширение. Чем больше мы, чем сильнее мы и успешнее, тем больше возможностей мы получаем", – напутствовал Яценюк лидеров ЕС.
Насчет "больше получаем" это он, конечно, правильно заметил. Украина так настойчиво бросается в объятия ЕС, что Европе становится даже неловко. А учитывая, что взамен Киев просит помочь материально, это становится еще и накладным. Уже один из главных проводников европейских ценностей в украинские степи, бывший президент Виктор Ющенко признал, что тема Украины настолько надоела мировому сообществу, что все стараются отмахнуться от неё как от назойливой мухи. В Киеве это чувствуют, поэтому стараются привлечь угасающее внимание новыми инициативами, одна забавнее другой. А когда и это не срабатывает, украинские власти срываются чуть ли не на истеричные требования. Денег, в первую очередь.
"Помогите Украине не словами, а долларами. Вернее, миллиардом долларов, — заявил Яценюк, комментируя принятие Радой закона о приостановке выплаты по внешнему долгу Украины, напугавшее западных инвесторов. — Этим законом Киев не говорит Западу о нежелании платить по долгам. Украина хочет заплатить, но на предлагаемых нами условиях. Мы не можем платить из карманов граждан нашей страны 40 миллиардов долларов, которые за время президентства умудрился взять в долг Виктор Янукович".
При этом в долг Украина активно брала и до Януковича, во время президентства Виктора Ющенко, при котором Арсений Яценюк занимал должность министра экономики Украины. Но он об этом предпочитает не вспоминать. Зато спешит напомнить западным кредиторам, что раз они давали в долг Януковичу, то теперь несут перед Украиной "моральную ответственность".
Насколько лидеры ЕС согласны с этим мнением, можно судить по одному лишь факту. Из черновика итоговой декларации рижского саммита "Восточного партнерства" исключены не только вопросы потенциального членства Украины, Грузии и Молдовы в ЕС, но даже и положения о безвизовом режиме для них в 2016 году. Это дает повод ожидать новых волнующих заявлений от украинской власти. Ждем с нетерпением.
Какое ваше мнение об этом?
А также - смотрите:
|
Метки: Financial Times экономика Financial украинцы политика украина новости москва грузия закон Вести Times НАТО СНБО Яценюк не |
Украинские военные стягивают "Грады" к Марьинке |
 Украинские военные стягивают вооружение к населенным пунктам Романовка и Марьинка. Как сообщает в пятницу представитель Минобороны ДНР Эдуард Басурин, разведка ополченцев выявила новые факты размещения тяжелого вооружения вдоль линии разграничения.
Украинские военные стягивают вооружение к населенным пунктам Романовка и Марьинка. Как сообщает в пятницу представитель Минобороны ДНР Эдуард Басурин, разведка ополченцев выявила новые факты размещения тяжелого вооружения вдоль линии разграничения.
|
Метки: вооружение романовка конфликт разведка политика украинцы марьинка Украина новости басурин обстрел футбол эдуард Вести Украинские военные |
Американец 492 раза попался на пьянстве в общественном месте |
 46-летний житель американского города Нэшвилл (штат Теннесси) Роберт Браун установил довольно сомнительный рекорд. За последние 20 лет мужчине удалось получить почти 500 штрафов за распитие спиртного в общественных местах. Браун в очередной раз оказался за решеткой, сообщает NY Daily News.
46-летний житель американского города Нэшвилл (штат Теннесси) Роберт Браун установил довольно сомнительный рекорд. За последние 20 лет мужчине удалось получить почти 500 штрафов за распитие спиртного в общественных местах. Браун в очередной раз оказался за решеткой, сообщает NY Daily News.
|
Метки: NY Daily News алкоголизм алкоголик спиртное распитие политика теннеси мужчина америка новости рекорд тюрьма закон Вести аретс Американец 492 |
Житель Самары поймал девочку, выпавшую с четвертого этажа |
 В Самаре 12-летняя девочка выпала с четвертого этажа и осталась жива. Мужчина из дома напротив заметил ребенка, готового сорваться с балкона, и вовремя поймал его. Девочка получила перелом позвонка и ушиб брюшной полости, но ее жизни ничто не угрожает.
В Самаре 12-летняя девочка выпала с четвертого этажа и осталась жива. Мужчина из дома напротив заметил ребенка, готового сорваться с балкона, и вовремя поймал его. Девочка получила перелом позвонка и ушиб брюшной полости, но ее жизни ничто не угрожает.
|
Метки: политика новости ребенок падение девочка самара балкон Вести Житель Самары |
Меркель устно пообещала Порошенко безвизовый режим |
 Ангела Меркель видит перспективы введения безвизового режима в страны Евросоюза для украинских граждан при условии выполнения Киевом всех условий. Об этом сообщил после встречи в Риге с канцлером Германии и президентом Франции Петр Порошенко.
Ангела Меркель видит перспективы введения безвизового режима в страны Евросоюза для украинских граждан при условии выполнения Киевом всех условий. Об этом сообщил после встречи в Риге с канцлером Германии и президентом Франции Петр Порошенко.
|
Метки: партнерство порошенко восточное германия политика украинцы украина Twitter франция новости латвия саммит Вести ТАСС Меркель устно |
МИД РФ ответит на запрет российским экспертам по ОМУ во въезде в Канаду |
 Отказ Канады в визах российским экспертам по нераспространению оружия массового поражения (ому) без ответа не останется, заявили в МИД РФ. Проблематика ОМУ слишком серьезная область международного взаимодействия, сведение политических счетов в этой области неуместно, отметили в МИД.
Отказ Канады в визах российским экспертам по нераспространению оружия массового поражения (ому) без ответа не останется, заявили в МИД РФ. Проблематика ОМУ слишком серьезная область международного взаимодействия, сведение политических счетов в этой области неуместно, отметили в МИД.
|
Метки: делегация политика россияне новости запрет Россия канада Вести въезд ГЭОВ визы ИБОР ому МИД РФ |
MixRadio: персональный диджей с платформы Windows Phone |
 На iPhone и Android-устройствах начал работу ранее доступный лишь на платформе Windows Phone музыкальный сервис MixRadio, который составляет подборки треков, отталкиваясь от изысканий пользователя. Функционал интернет-радио построен вокруг "миксов" — плей-листов, которые формируются с учетом персональных рекомендаций.
На iPhone и Android-устройствах начал работу ранее доступный лишь на платформе Windows Phone музыкальный сервис MixRadio, который составляет подборки треков, отталкиваясь от изысканий пользователя. Функционал интернет-радио построен вокруг "миксов" — плей-листов, которые формируются с учетом персональных рекомендаций.
|
|
Bundle: защищенная фотобиблиотека на смартфоне |
 На Android и iOS вышел медиабраузер Bundle, который позволяет удобно управлять и делиться фотографиями, хранящимися на устройстве. Часто бывает, когда друзья или члены семьи делают снимки с одного и того же события, например — отпуска или вечеринки. Однако возможность снова собраться вместе и просмотреть их возникает довольно редко.
На Android и iOS вышел медиабраузер Bundle, который позволяет удобно управлять и делиться фотографиями, хранящимися на устройстве. Часто бывает, когда друзья или члены семьи делают снимки с одного и того же события, например — отпуска или вечеринки. Однако возможность снова собраться вместе и просмотреть их возникает довольно редко.
|
|
КХЛ закрыла сезон церемонией награждения победителей |
 Хоккейный сезон завершен и, без сомнения, он был лучший в истории КХЛ, следующий будет еще лучше. Но сейчас — время подвести итоги и раздать хоккейные награды. Перед началом церемонии закрытия президент КХЛ Дмитрий Чернышенко сохраняет олимпийское спокойствие и это при том, что в качестве хозяина церемонии он выступает впервые.
Хоккейный сезон завершен и, без сомнения, он был лучший в истории КХЛ, следующий будет еще лучше. Но сейчас — время подвести итоги и раздать хоккейные награды. Перед началом церемонии закрытия президент КХЛ Дмитрий Чернышенко сохраняет олимпийское спокойствие и это при том, что в качестве хозяина церемонии он выступает впервые.
|
Метки: гагарина политика новости хоккей кубок Вести спорт кони ЦСКА СКА кхл НХЛ закрыла |
Велоспорт. Александр Кристофф выиграл второй этап "Тура Норвегии" |
 Лидер команды Мирового Тура "Катюша" Александр Кристофф одержал свою вторую подряд победу на многодневной гонке "Тур Норвегии". В четверг Кристофф уверенно выиграл 2-й этап с финишем в Лангесунде, сохранив при этом желтую майку лидера общего зачета.
Лидер команды Мирового Тура "Катюша" Александр Кристофф одержал свою вторую подряд победу на многодневной гонке "Тур Норвегии". В четверг Кристофф уверенно выиграл 2-й этап с финишем в Лангесунде, сохранив при этом желтую майку лидера общего зачета.
|
Метки: Team Joker велоспорт GreenEdge Александр Кристофф политика Норвегии новости Катюша Joker Вести Team тур 185 199 Велоспорт. |
Военный концерн "Алмаз-Антей" подал жалобу в суд на санкции ЕС |
 Российский концерн "Алмаз – Антей", специализирующийся на производстве ПВО, в административном и судебном порядке обжаловал санкции Европейского союза от июля и сентября 2014 года.
Российский концерн "Алмаз – Антей", специализирующийся на производстве ПВО, в административном и судебном порядке обжаловал санкции Европейского союза от июля и сентября 2014 года.
|
|
В Новосибирской области на поддержку малого бизнеса выделят 500 млн рублей |
 Губернатор Владимир Городецкий отметил ведущие позиции Новосибирской области среди регионов Сибири по развитию малого и среднего бизнеса.
Губернатор Владимир Городецкий отметил ведущие позиции Новосибирской области среди регионов Сибири по развитию малого и среднего бизнеса.
|
Метки: экономика политика новости закон Вести 2015 560 435 125 500 140 Новосибирской |
В Дзержинске самосвал с песком опрокинулся на маршрутку |
 Самосвал с песком опрокинулся на маршрутку в Нижегородской области.
Самосвал с песком опрокинулся на маршрутку в Нижегородской области.
|
Метки: политика новости Вести ДТП Дзержинске |
Васильевой предложили защищать права женщин за решеткой |
 Евгении Васильевой, отбывающей срок в СИЗО №6, предложили стать правозащитницей. С предложением вступить в свои ряды и начать помогать осужденным женщинам выступила руководитель общественной организации "Правовая зона" Елена Соколова.
Евгении Васильевой, отбывающей срок в СИЗО №6, предложили стать правозащитницей. С предложением вступить в свои ряды и начать помогать осужденным женщинам выступила руководитель общественной организации "Правовая зона" Елена Соколова.
|
|
Мозг выдающихся спортсменов работает на 82% быстрее |
 Результаты нового исследования показали: у профессиональных спортсменов область мозга, отвечающая за скорость реакции, работает на 82% быстрее, чем у среднестатистического человека.
Результаты нового исследования показали: у профессиональных спортсменов область мозга, отвечающая за скорость реакции, работает на 82% быстрее, чем у среднестатистического человека.
|
|
В рамках кинофестиваля забайкальским зрителям покажут стоминутный фильм-сюрприз |
 В Чите продолжает свою работу пятый Забайкальский Международный кинофестиваль. 21 мая прошла торжественная церемония открытия кинофорума. В первый же день еще за несколько часов до открытия грандиозного мероприятия на читинских площадках были представлены нескольких картин фестиваля. Одна из них входит в конкурсную программу «Новый взгляд». Это фильм французского режиссера Лорана Тирара «Каникулы маленького Николя». К слову, на юбилейном фестивале будут показаны свыше десяти детских картин, в том числе и пять мультипликационных фильмов от «Союзмультфильма».
В Чите продолжает свою работу пятый Забайкальский Международный кинофестиваль. 21 мая прошла торжественная церемония открытия кинофорума. В первый же день еще за несколько часов до открытия грандиозного мероприятия на читинских площадках были представлены нескольких картин фестиваля. Одна из них входит в конкурсную программу «Новый взгляд». Это фильм французского режиссера Лорана Тирара «Каникулы маленького Николя». К слову, на юбилейном фестивале будут показаны свыше десяти детских картин, в том числе и пять мультипликационных фильмов от «Союзмультфильма».
|
Метки: политика россияне новости Франция Россия Вести РСФСР РФ рамках |
Адвокат: новый подозреваемый по делу Немцова фигурирует в расследовании давно |
 Следствие проверяет уроженца Чечни Руслана Мухудинова на причастность к убийству Бориса Немцова. Сейчас устанавливается его местонахождение. Между тем, адвокат потерпевших Вадим Прохоров опроверг сообщения о том, что Мухудинов – новый фигурант дела.
Следствие проверяет уроженца Чечни Руслана Мухудинова на причастность к убийству Бориса Немцова. Сейчас устанавливается его местонахождение. Между тем, адвокат потерпевших Вадим Прохоров опроверг сообщения о том, что Мухудинов – новый фигурант дела.
|
Метки: Charlie Hebdo мухудинов россияне фигурант политика убийство Франция Адвокат новости Charlie руслан допрос Россия немцов Вести новый |










